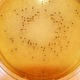
Lab M listeria media range
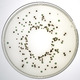
Salmonella

The company is now offering its immunomagnetic Captivate O121 system which detects and isolates E-coli.
The latest testing capabilities are designed to meet strict food product testing in meat products required by USA law.
Although the most common serogroups of STEC in Europe and the USA are E. coli O157 or O26, the incidence of other serotypes is increasing.
The six major non-O157 STECs identified in the USA are O26, O45, O103, O111, O121 and O145.
One of the challenges with E. coli O121 in particular is that it is not biochemically unique.
Therefore, it is difficult to isolate from other STEC strains using conventional culture methods, whereas the use of IMS supports the specific isolation of E. coli O121.